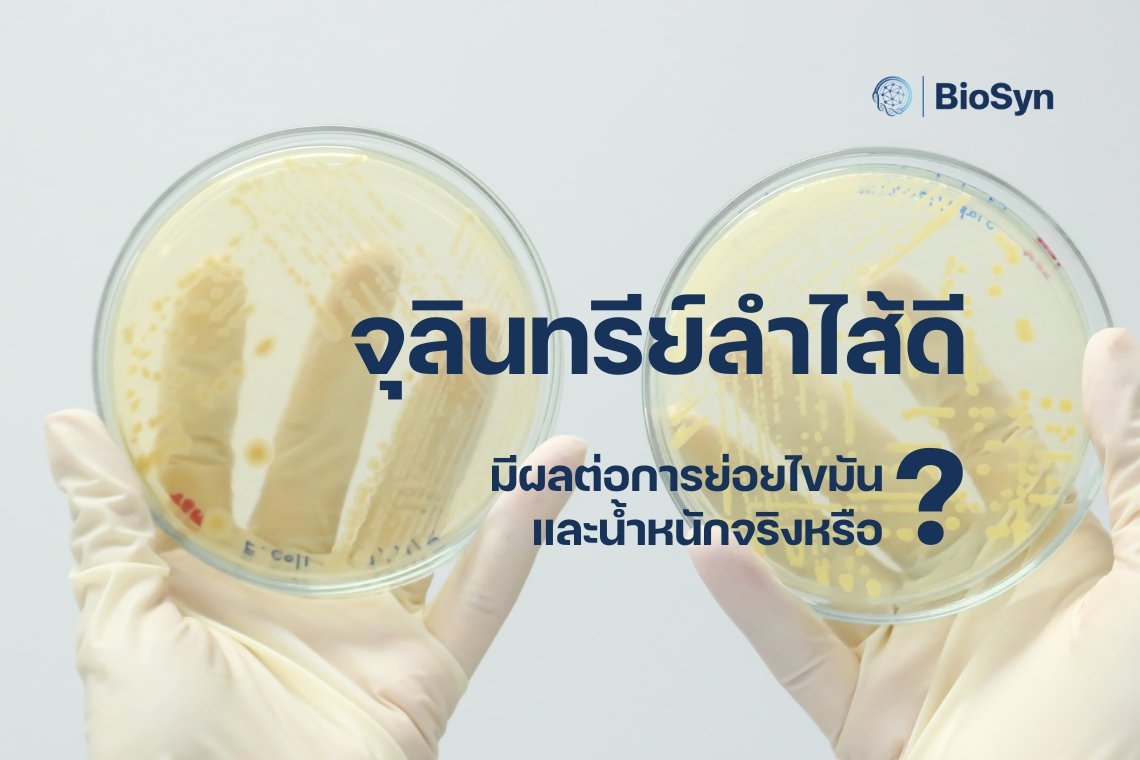
จุลินทรีย์ลำไส้ดี มีผลต่อการย่อยไขมันและน้ำหนักจริงหรือ? จุลินทรีย์ลำไส้ดี มีผลต่อการย่อยไขมันและน้ำหนักจริงหรือ?

จุลินทรีย์ลำไส้ดี มีผลต่อการย่อยไขมันและน้ำหนักจริงหรือ?
Last updated: 18 ก.ค. 2568 | 609 จำนวนผู้เข้าชม |
เคยสงสัยไหมว่าทำไมบางคนกินเท่าไหร่ก็ไม่อ้วน แต่บางคนแค่ดื่มน้ำก็เหมือนน้ำหนักพุ่ง? ปัจจัยหนึ่งที่อาจถูกมองข้ามมากที่สุดในสมการควบคุมน้ำหนักคือ “จุลินทรีย์ในลำไส้” หรือ Gut Microbiota ที่อยู่อาศัยนับล้านล้านตัวในระบบทางเดินอาหารของเรา
แม้เราจะกินอาหารเหมือนกัน ออกกำลังกายใกล้เคียงกัน แต่ “องค์ประกอบของจุลินทรีย์ในลำไส้” ที่แตกต่างกันอาจเป็นตัวกำหนดว่าใครจะสะสมไขมัน ใครจะเผาผลาญไขมัน และใครจะมีแนวโน้มอ้วนได้ง่ายกว่ากันอย่างชัดเจน
บทความนี้จะพาคุณเจาะลึกงานวิจัยระดับโลกที่ชี้ชัดว่า จุลินทรีย์ลำไส้ดี ไม่เพียงแต่ช่วยย่อยอาหาร แต่ยังมีอิทธิพลต่อการย่อยไขมัน การสะสมพลังงาน และแม้แต่การควบคุมน้ำหนักตัวในระยะยาว
ทำความรู้จัก “จุลินทรีย์ในลำไส้” ผู้ควบคุมพลังงานแบบเงียบ ๆ
ในลำไส้ของมนุษย์ มีจุลินทรีย์อาศัยอยู่มากกว่า 100 ล้านล้านตัว ครอบคลุมทั้งแบคทีเรียชนิดดีและชนิดไม่ดี โดยเฉพาะกลุ่มหลักอย่าง Firmicutes และ Bacteroidetes ซึ่งเป็นตัวแปรสำคัญของสุขภาพ
Firmicutes มีแนวโน้มช่วยให้ร่างกาย ดูดซึมพลังงานได้มากขึ้น จากอาหารที่รับประทาน
Bacteroidetes มีบทบาทช่วยในการ สลายไขมันและใยอาหาร ให้กลายเป็นพลังงานที่ใช้ได้เร็ว
งานวิจัยพบว่า ผู้ที่มีสัดส่วน Firmicutes มากกว่า Bacteroidetes มักมี BMI สูงกว่า และมีแนวโน้มอ้วนง่ายกว่าโดยไม่รู้ตัว
จุลินทรีย์ดีช่วยอะไรในเรื่อง “การย่อยไขมัน”?
การย่อยไขมันไม่ได้เป็นแค่กระบวนการของเอนไซม์จากตับและตับอ่อนเท่านั้น แต่จุลินทรีย์บางชนิด เช่น Lactobacillus และ Bifidobacterium มีบทบาทในการ:
ช่วยกระตุ้นการผลิตกรดน้ำดีเพื่อย่อยไขมันให้แตกตัวดีขึ้น
สลายไขมันชนิดไม่ดี และส่งเสริมการเผาผลาญไขมันในร่างกาย
ลดการดูดซึมไขมันเข้าสู่ร่างกายในระดับที่มากเกินไป
จุลินทรีย์เหล่านี้ยังส่งผลต่อฮอร์โมนความอิ่ม เช่น GLP-1 และ PYY ที่ทำให้รู้สึกอิ่มไวขึ้น กินน้อยลง และช่วยควบคุมแคลอรี่โดยอัตโนมัติ
จุลินทรีย์เสียสมดุล = เผาผลาญช้าลง อ้วนง่ายขึ้น
เมื่อสมดุลจุลินทรีย์ในลำไส้ถูกรบกวน เช่น จาก
• การกินอาหารไขมันสูง น้ำตาลสูง
• การใช้ยาปฏิชีวนะหรือยาลดกรด
• ความเครียดและการนอนหลับไม่เพียงพอ
ผลลัพธ์ที่ตามมาคือ...
• การสะสมพลังงานเพิ่มขึ้น (แม้จะกินเท่าเดิม)
• การเกิดการอักเสบเรื้อรังในลำไส้ ส่งผลให้ดื้อต่ออินซูลิน
• ความอยากอาหารเพิ่มขึ้นจากการรบกวนฮอร์โมน leptin และ ghrelin
ทั้งหมดนี้เป็นปัจจัยที่ทำให้คุณ "อ้วนง่ายแต่ผอมยาก" โดยที่คุณอาจไม่รู้เลยว่าต้นเหตุคือ “ลำไส้ของคุณเอง”
สุขภาพลำไส้ดี = ย่อยไขมันได้ดี คุมน้ำหนักได้อยู่หมัด
หากคุณรู้สึกว่า “กินน้อยแต่น้ำหนักไม่ลง” หรือ “ย่อยไขมันได้ยาก ท้องอืดง่ายหลังมื้ออาหาร” อย่าเพิ่งรีบโทษระบบเผาผลาญหรือพันธุกรรม แต่อาจถึงเวลาที่ต้องหันกลับมาดูแล “จุลินทรีย์ในลำไส้”
BioSyn เป็นตัวช่วยที่ออกแบบมาเพื่อปรับสมดุลจุลินทรีย์ในลำไส้อย่างเป็นธรรมชาติ เพื่อให้ร่างกายของคุณย่อยไขมันได้ดี เผาผลาญไว และควบคุมน้ำหนักได้อย่างยั่งยืน
เสริมสมดุลลำไส้ ฟื้นสุขภาพจากภายใน ด้วย BioSyn “ดูแลลำไส้วันนี้ เพื่อสุขภาพน้ำหนักที่ยั่งยืนในวันหน้า”
ช้อปออนไลน์ได้เลยที่ :
Inbox : m.me/BioSynThailand
Line Shopping : https://shop.line.me/@biosyn
Shopee : BioSyn Official : https://shopee.co.th/biosyn_official
Lazada : BioSyn Thailand : https://bit.ly/3SXeQpz
แหล่งอ้างอิง
1. Turnbaugh PJ, et al. (2006). An obesity-associated gut microbiome with increased capacity for energy harvest. Nature.
2. Aron-Wisnewsky J, et al. (2012). Gut microbiota and human nutrition. British Journal of Nutrition.
3. Clarke SF, et al. (2014). Exercise and associated dietary extremes impact on gut microbial diversity. Gut.
4. Kootte RS, et al. (2017). Improvement of Insulin Sensitivity after Lean Donor Feces in Metabolic Syndrome Is Driven by Baseline Intestinal Microbiota Composition. Cell Metabolism.
เรียบเรียงโดย: BioSyn Thailand



